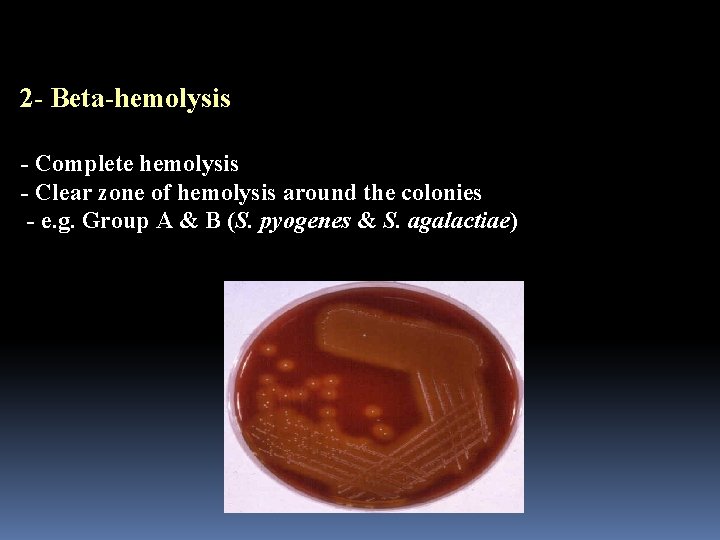
2 - Beta-hemolysis - Complete hemolysis - Clear zone of hemolysis around the colonies
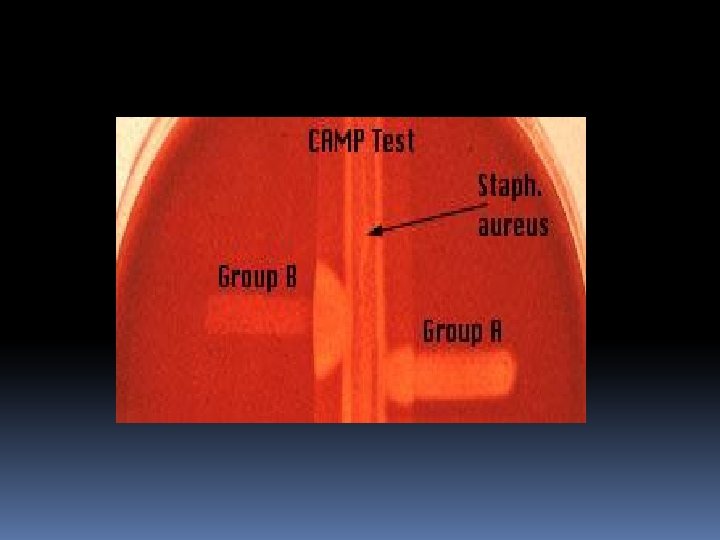
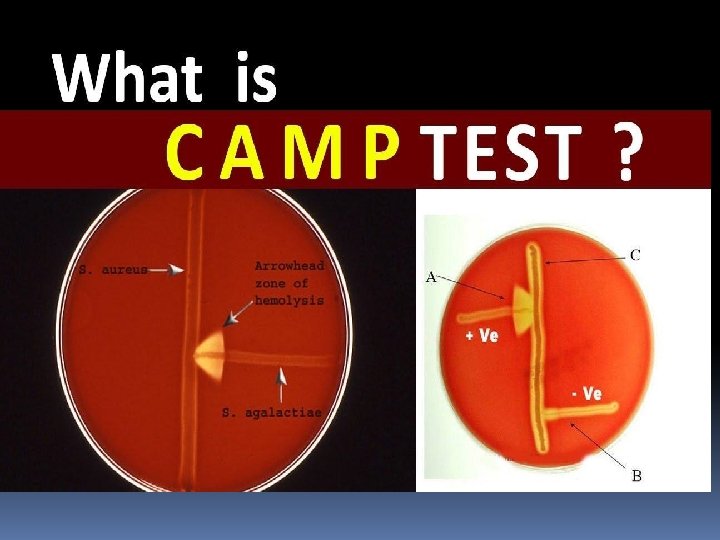
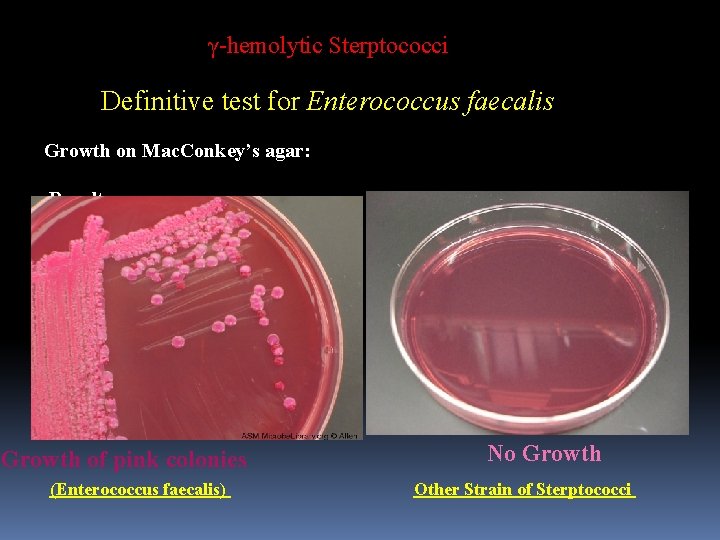
γ-hemolytic Sterptococci Definitive test for Enterococcus faecalis Growth on Mac. Conkey’s agar: Results: Growth
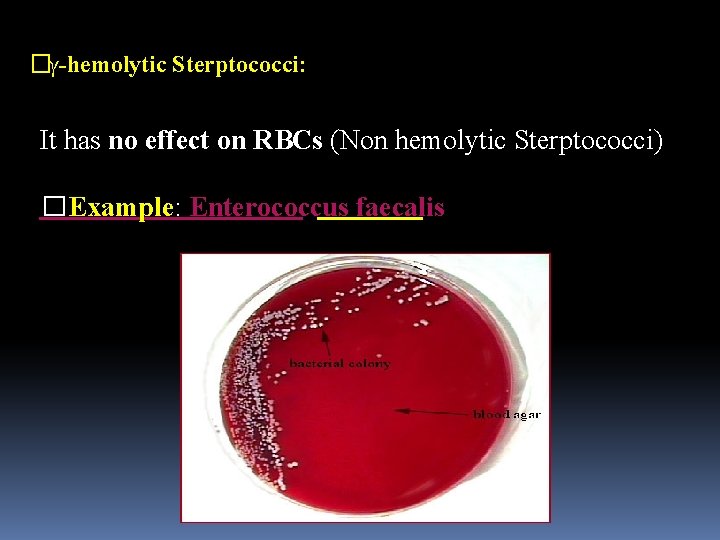
�γ-hemolytic Sterptococci: It has no effect on RBCs (Non hemolytic Sterptococci) �Example: Enterococcus faecalis

Classification of Bacteria GramPositive Gramnegative GramPositive Bacteria I

Classification of Bacteria Gram-Positive Gram-negative

Gram-Positive Bacteria I- Gram Positive bacteria A- Gram positive cocci B- Gram positive rods Non spore-forming Corynebacterium Spore-forming Aerobic Bacillus anthracis Anaerobic Clostridium

Gram-Positive Cocci A- Gram-positive cocci I- staphylococci II- streptococci

II- Streptococci Characters of Streptococci - Gram positive cocci Chains or pairs - Usually capsulated - Non motile - Non spore forming - Facultative anaerobes - Fastidious - Catalase negative (Staphylococci are catalase positive)

Classification of Streptococci can be classified according to: Streptococci Oxygen requirements 1 - Anaerobic 2 - Aerobic 3 -facultative anaerobic Serology (Lanciefield Classification) Hemolysis on Blood Agar (BA)

Serology (Lanciefield Classification) **There are 20 described serotypes, named Lancefield groups A to V, which describes specific carbohydrates present on the bacterial cell wall. **Lancefield groups A and B include the significant streptococcal pathogens of humans Beta hemolytic streptococci **There is Non-groupable streptococci ; S. pneumoniae (pneumonia) and viridans streptococci

Hemolysis on Blood Agar (BA) 1 - Alpha-hemolysis - Partial hemolysis - Green discoloration around the colonies - e. g. non-groupable streptococci (S. pneumoniae & S. viridans)
2 - Beta-hemolysis - Complete hemolysis - Clear zone of hemolysis around the colonies - e. g. Group A & B (S. pyogenes & S. agalactiae)

3 - Gamma-hemolysis No lysis e. g. Group D (Enterococcus spp)


Experimental 1 - Gram stain of streptococci 2 - Catalase 3 - Hemolysis on blood agar (alpha, Beta, and Ghama hemolysis) 4 - Bacitracin susceptibility test 5 - Optochin susceptibility test

Macroscopical Examination

Catalase Test

Growth on Blood Agar Sterptococci are divided into three main groups accorging to its action on erythrocytes: β-hemolytic Sterptococci α-hemolytic Sterptococci. γ-hemolytic Sterptococci. β-hemolytic Sterptococci Definitive test to differentiate between S. Pyogenes & Non group A β-hemolytic Streptococci

Growth on Blood Agar β-hemolytic Sterptococci: - It causes complete hemolysis to RBCs leading to formation of clear zone around the colonies -Example Strept. Pyogenes (group A β-hemolytic Strept. )

Bacitracin Sensitivity Test: *Differentiation between Beta-hemolytic streptococci Definitive test to differentiate between S. Pyogenes & Non group A β-hemolytic Streptococci Principle: A low conc. of Bacitracin (0. 04 units) will selectively inhibit the growth of S. pyogenes giving a zone of inhibition around the disc.

Procedure: Inoculate blood agar plate with the test organism. Aseptically apply Bacitracin disc onto the center of the streaked area Incubate the plate at 35 o. C for 18 hrs Results: Positive test: any zone of inhibition around the disc.

CAMP test Principle: – Group B streptococci produce extracellular protein (CAMP factor) – CAMP act synergistically with staph. - lysin to cause lysis of RBCs - Procedure: – Single streak of Streptococcus to be tested and a Staph. aureus are made perpendicular to each other – 3 -5 mm distance was left between two streaks –After incubation, a positive result appear as an arrowhead shaped zone of complete hemolysis –S. agalactiae is CAMP test positive while non gp B streptococci are negative Manal Al

Group A streptococci - Pathogenesis and Virulence Factors Group A streptococci Structural components 1 - protein M 2 - Lipoteichoic acid & F protein 3 -Hyaluronic acid capsule, which acts to camouflage the bacteria Enzymes Streptokinases Deoxynucleases C 5 a peptidase Pyrogenic toxins Streptolysin O lyse red blood cells, white blood cells, and platelets Streptolysin S

α-hemolytic Sterptococci: It causes: 1. Partial hemolysis to RBCs. 2. Act enzymatically on blood pigment leading to green discoloration around the colonies. - Example: Strept. Pneumonia, viridans Streptococci.

α-hemolytic Sterptococci: Definitve test to differentiate between S. Pneumoniae & Viridans Streptococci Optochin Sensitivity Test: Principle: S. Pneumoniae is inhibited by less than 5 mg. Lml Optochin reagent giving a zone of inhibition more than 15 mm in diameter.

α-hemolytic Sterptococci: Optochin Sensitivity Test: Procedure: 1 - Inoculate blood agar plate with the test organism. 2 - Aseptically apply Optochin disc onto the center of the streaked area. 3 - Incubate the plate at 35 C for 18 hrs. 4 - Accurately measure the diameter of the inhibition Zone around the disc.

Optochin Sensitivity Test: Result: (+) Positive test: inhibition zone more than 15 mm in diameter. Optochin sensitive S. pneumoniae (+) Optochin resistant Viridans Streptococci (-)

α-hemolytic Sterptococci 2. Bile Solubility Test: Principle: S. Pneumoniae produce a self-lysing enzyme to depress the growth of old colonies. The presence of bile salt accelerate this process.

α-hemolytic Sterptococci Procedure: 1 -10 ml broth culture of the test organism 2 - Add 1 ml 10% bile salt solutio 3. Incubate at 37 o. C for 15 min. 4 - Observe for the visible clearing of the turbid culture.

α-hemolytic Streptococci 2. Bile Solubility Test Results: Positive test: Visible clearance of the turbid culture Visible clearance S. Pneumoniae Remain turbid Viridans Streptococci
γ-hemolytic Sterptococci Definitive test for Enterococcus faecalis Growth on Mac. Conkey’s agar: Results: Growth on Mac. Conkey’s agar: Growth of pink colonies (Enterococcus faecalis) No Growth Other Strain of Sterptococci

Practical Work 1 -Gram’s Stain (spots) 2. Catalase test 3. Blood agar plate. 4. Bacitracin & Optochin Sensitivity. 5. Mac. Conkey’s agar plate.
�γ-hemolytic Sterptococci: It has no effect on RBCs (Non hemolytic Sterptococci) �Example: Enterococcus faecalis

Optochin Sensitivity Test: ***Differentiation between Alpha-hemolytic streptococci Definitive test to differentiate between S. Pneumoniae & Viridans Streptococci Principle S. Pneumoniae is inhibited by less than 5 μg/ml Optochin reagent giving a zone of inhibition more than 15 mm in diameter. Procedure: 1. Inoculate blood agar plate with the test organism. 2. Aseptically apply Optochin disc onto the center of the streaked area. 3. Incubate the plate at 35 o. C for 18 hrs. 4. Accurately measure the diameter of the inhibition zone around the disc.

***Definitive test for Enterococcus faecalis (Gamma hemolytic streptococci Growth on Mac. Conkey’s agar: ****Principle: �Mac. Conkey’s agar is a selective medium for Gram’s –ve bacteria. �It contains bile salt and crystal violet to inhibit the growth of Gram’s +ve bacteria. �Enterococcus faecalis is the only Streptococcus species which can grow on Mac. Conkey’s agar giving pink colonies.
- Slides: 33